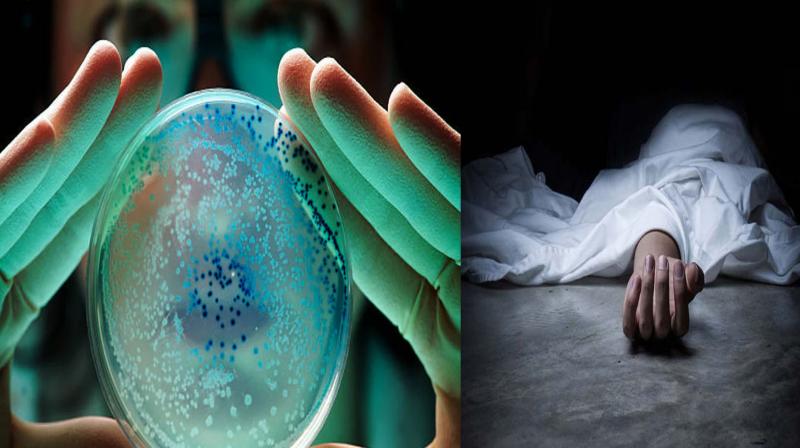
Five types of bacteria claimed 6.8 lakh lives in India in 2019: Lancet study

विश्लेषण में पाया गया कि सामान्य जीवाणु संक्रमण 2019 में मृत्यु का दूसरा प्रमुख कारण था, और विश्व स्तर पर हर आठ मौतों में से एक इससे संबंधित थी।
New Delhi : भारत में 2019 में पांच प्रकार के जीवाणुओं- ई कोलाई, एस.निमोनिया, के.निमोनिया, एस. ऑरियस और ए. बाउमानी- के कारण करीब 6.8 लाख लोगों की जान गई। पत्रिका ‘द लैंसेट’ द्वारा प्रकाशित एक अध्ययन में यह बात सामने आई।
विश्लेषण में पाया गया कि सामान्य जीवाणु संक्रमण 2019 में मृत्यु का दूसरा प्रमुख कारण था, और विश्व स्तर पर हर आठ मौतों में से एक इससे संबंधित थी।
शोधकर्ताओं ने कहा कि 2019 में 33 सामान्य जीवाणु संक्रमणों से संबंधित 77 लाख मौत हुईं, जिनमें अकेले पांच जीवाणु आधे से अधिक मौतों से जुड़े थे। उन्होंने कहा कि सबसे घातक जीवाणु रोगजनक और संक्रमण के प्रकार स्थान और उम्र के अनुसार भिन्न होते हैं।
शोधकर्ताओं के मुताबिक भारत में पांच जीवाणु - ई कोलाई, एस.निमोनिया, के.निमोनिया, एस. ऑरियस और ए. बाउमानी- सबसे घातक पाए गए जिनकी वजह से अकेले 2019 में 6,78,846 (करीब 6.8 लाख) लोगों की जान गई।
अध्ययन के अनुसार, ई कोलाई सबसे घातक रोगजनक था जिसके चलते भारत में 2019 में 1,57,082 (1.57 लाख) लोगों की जान गई।.अध्ययन में पाया गया कि वैश्विक तौर पर जीवाणु संक्रमण 2019 में मृत्यु के प्रमुख कारण के रूप में इस्केमिक हृदय रोग के बाद दूसरे स्थान पर था।
शोधकर्ताओं ने कहा कि अधिक नैदानिक प्रयोगशाला क्षमता के साथ मजबूत स्वास्थ्य प्रणालियों का निर्माण, नियंत्रक उपायों को लागू करना, और एंटीबायोटिक के उपयोग को अनुकूलित करना आम जीवाणु संक्रमण के कारण होने वाली बीमारी के बोझ को कम करने के लिहाज से महत्वपूर्ण है।
अमेरिका के वाशिंगटन विश्वविद्यालय के स्कूल ऑफ मेडिसिन में इंस्टीट्यूट फॉर हेल्थ मेट्रिक्स एंड इवेलुएशन (आईएचएमई) के निदेशक और अध्ययन के सह-लेखक क्रिस्टोफर मुर्रे ने कहा, “ये नए आंकड़े पहली बार जीवाणु संक्रमण से उत्पन्न वैश्विक सार्वजनिक स्वास्थ्य चुनौती की पूरी सीमा को प्रकट करते हैं।”
मुर्रे ने एक बयान में कहा, “इन परिणामों को वैश्विक स्वास्थ्य पहलों के रडार पर रखना अत्यंत महत्वपूर्ण है ताकि इन घातक रोगजनकों का गहराई से विश्लेषण किया जा सके और मौतों व संक्रमणों की संख्या को कम करने के लिए उचित कदम उठाए जा सकें।”.
शोधकर्ताओं ने कहा कि तपेदिक, मलेरिया और एचआईवी जैसे रोगजनकों के लिए कई आकलन मौजूद हैं लेकिन अब तक, जीवाणु रोगजनकों के रोग के भार का अनुमान कुछ विशिष्ट रोगजनकों और संक्रमण के प्रकारों तक सीमित था या केवल विशिष्ट आबादी पर केंद्रित था।.
उन्होंने कहा कि 2019 में एचआईवी / एड्स (864,000 मौतों) की तुलना में अधिक मौतें दो सबसे घातक रोगजनकों - एस. ऑरियस और ई. कोलाई से जुड़ी थीं। .
नया अध्ययन 33 सामान्य जीवाणु रोगजनकों और 11 प्रमुख संक्रमण प्रकारों से जुड़ी मृत्यु दर का पहला वैश्विक अनुमान प्रदान करता है - जिसे संक्रामक सिंड्रोम के रूप में जाना जाता है - जिससे सेप्सिस से मृत्यु हो जाती है।.
यह आकलन 204 देशों और क्षेत्रों में सभी उम्र और लिंगों के लिए तैयार किए गए थे।
ग्लोबल बर्डन ऑफ डिजीज 2019 और ग्लोबल रिसर्च ऑन एंटीमाइक्रोबियल रेजिस्टेंस (जीआरएएम) अध्ययनों से आंकड़ों और विधियों का उपयोग करते हुए शोधकर्ताओं ने प्रत्येक रोगजनक से जुड़ी मौतों और जिम्मेदार संक्रमण के प्रकार का अनुमान लगाने के लिए 34.3 करोड़ व्यक्तिगत रिकॉर्ड और ‘पैथोजन आइसोलेट्स’ का उपयोग किया।
2019 की अनुमानित 1.37 करोड़ संक्रमण से संबंधित मौतों में से मौत के 77 लाख मामले अध्ययन वाले 33 जीवाणु रोगजनकों से जुड़े थे।
अध्ययनकर्ताओं ने पाया कि जीवाणुओं से संबंधित मौत के 77 लाख मामलों में से 75 प्रतिशत की मौत तीन सिंड्रोम - लोअर रेसपिरेटरी इंफेक्शंस (एलआरआई), ब्लडस्ट्रीम इंफेक्शंस (बीएसआई) और पेरिटोनल एंड इंट्रा एब्डोमिनल इंफेक्शंस (आईएए) - के कारण हुई।.
उन्होंने कहा कि जिन जीवाणुओं का अध्ययन किया गया उनमें से पांच रोगजनक- ई कोलाई, एस.निमोनिया, के.निमोनिया, एस. ऑरियस और ए. बाउमानी- 54.2 प्रतिशत मौत के लिये जिम्मेदार थे।















